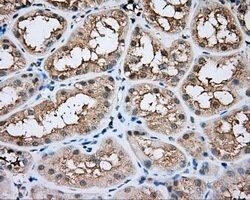
BTK Mouse anti-Human, Clone: OTI3D11, lyophilized, TrueMAB 100 &mu;g; Unconjugated:Antibodies,

Learn More
BTK Mouse anti-Human, Clone: OTI3D11, lyophilized, TrueMAB™
Mouse Monoclonal Antibody
Brand: Origene Technologies CF501092

Description
Reconstitute with PBS (pH 7.3) and recommend to perform another round of desalting process using Product No. 7KMWCO
BTK (Bruton′s tyrosine kinase or tyrosine-protein kinase BTK) was initially identified as a member of the src family for protein-tyrosine kinases that was involved in X-linked a-gamma-globulinaemia, and has since been shown to be involved in a number of signaling pathways in hemapoietic lineage. It has recently been shown to interact with members of the toll-like receptor (TLR) family such as TLR4, 6, 8, and 9. The TLRs are critical molecules in both the innate and adaptive immunity and can recognize diverse microbial pathogens. BTK has also been shown to interact with key proteins involved in TLR4 signal transduction such as MyD88, TIRAP, and IRAK, but not TRAF-6, suggesting that BTK is involved in lipopolysaccharide signal transduction. Mutations in this gene cause X-linked agammaglobulinemia type 1, which is an immunodeficiency characterized by the failure to produce mature B lymphocytes, and associated with a failure of Ig heavy chain rearrangement.Specifications
| BTK | |
| Monoclonal | |
| Unconjugated | |
| BTK | |
| AGMX1, AT, ATK, BPK, IMD1, PSCTK1, XLA | |
| Mouse | |
| Affinity Chromatography | |
| RUO | |
| 695 | |
| -20° C, Avoid Freeze/Thaw Cycles | |
| Lyophilized |
| Flow Cytometry, Immunocytochemistry, Immunofluorescence, Immunohistochemistry (Paraffin), Western Blot | |
| OTI3D11 | |
| PBS with 8% trehalose and no preservative; pH 7.3 | |
| Q06187 | |
| BTK | |
| Full length human recombit protein of human BTK produced in HEK293T cell. | |
| 100 μg | |
| Primary | |
| Human | |
| Antibody | |
| IgG3 |
The Fisher Scientific Encompass Program offers items which are not part of our distribution portfolio. These products typically do not have pictures or detailed descriptions. However, we are committed to improving your shopping experience. Please use the form below to provide feedback related to the content on this product.